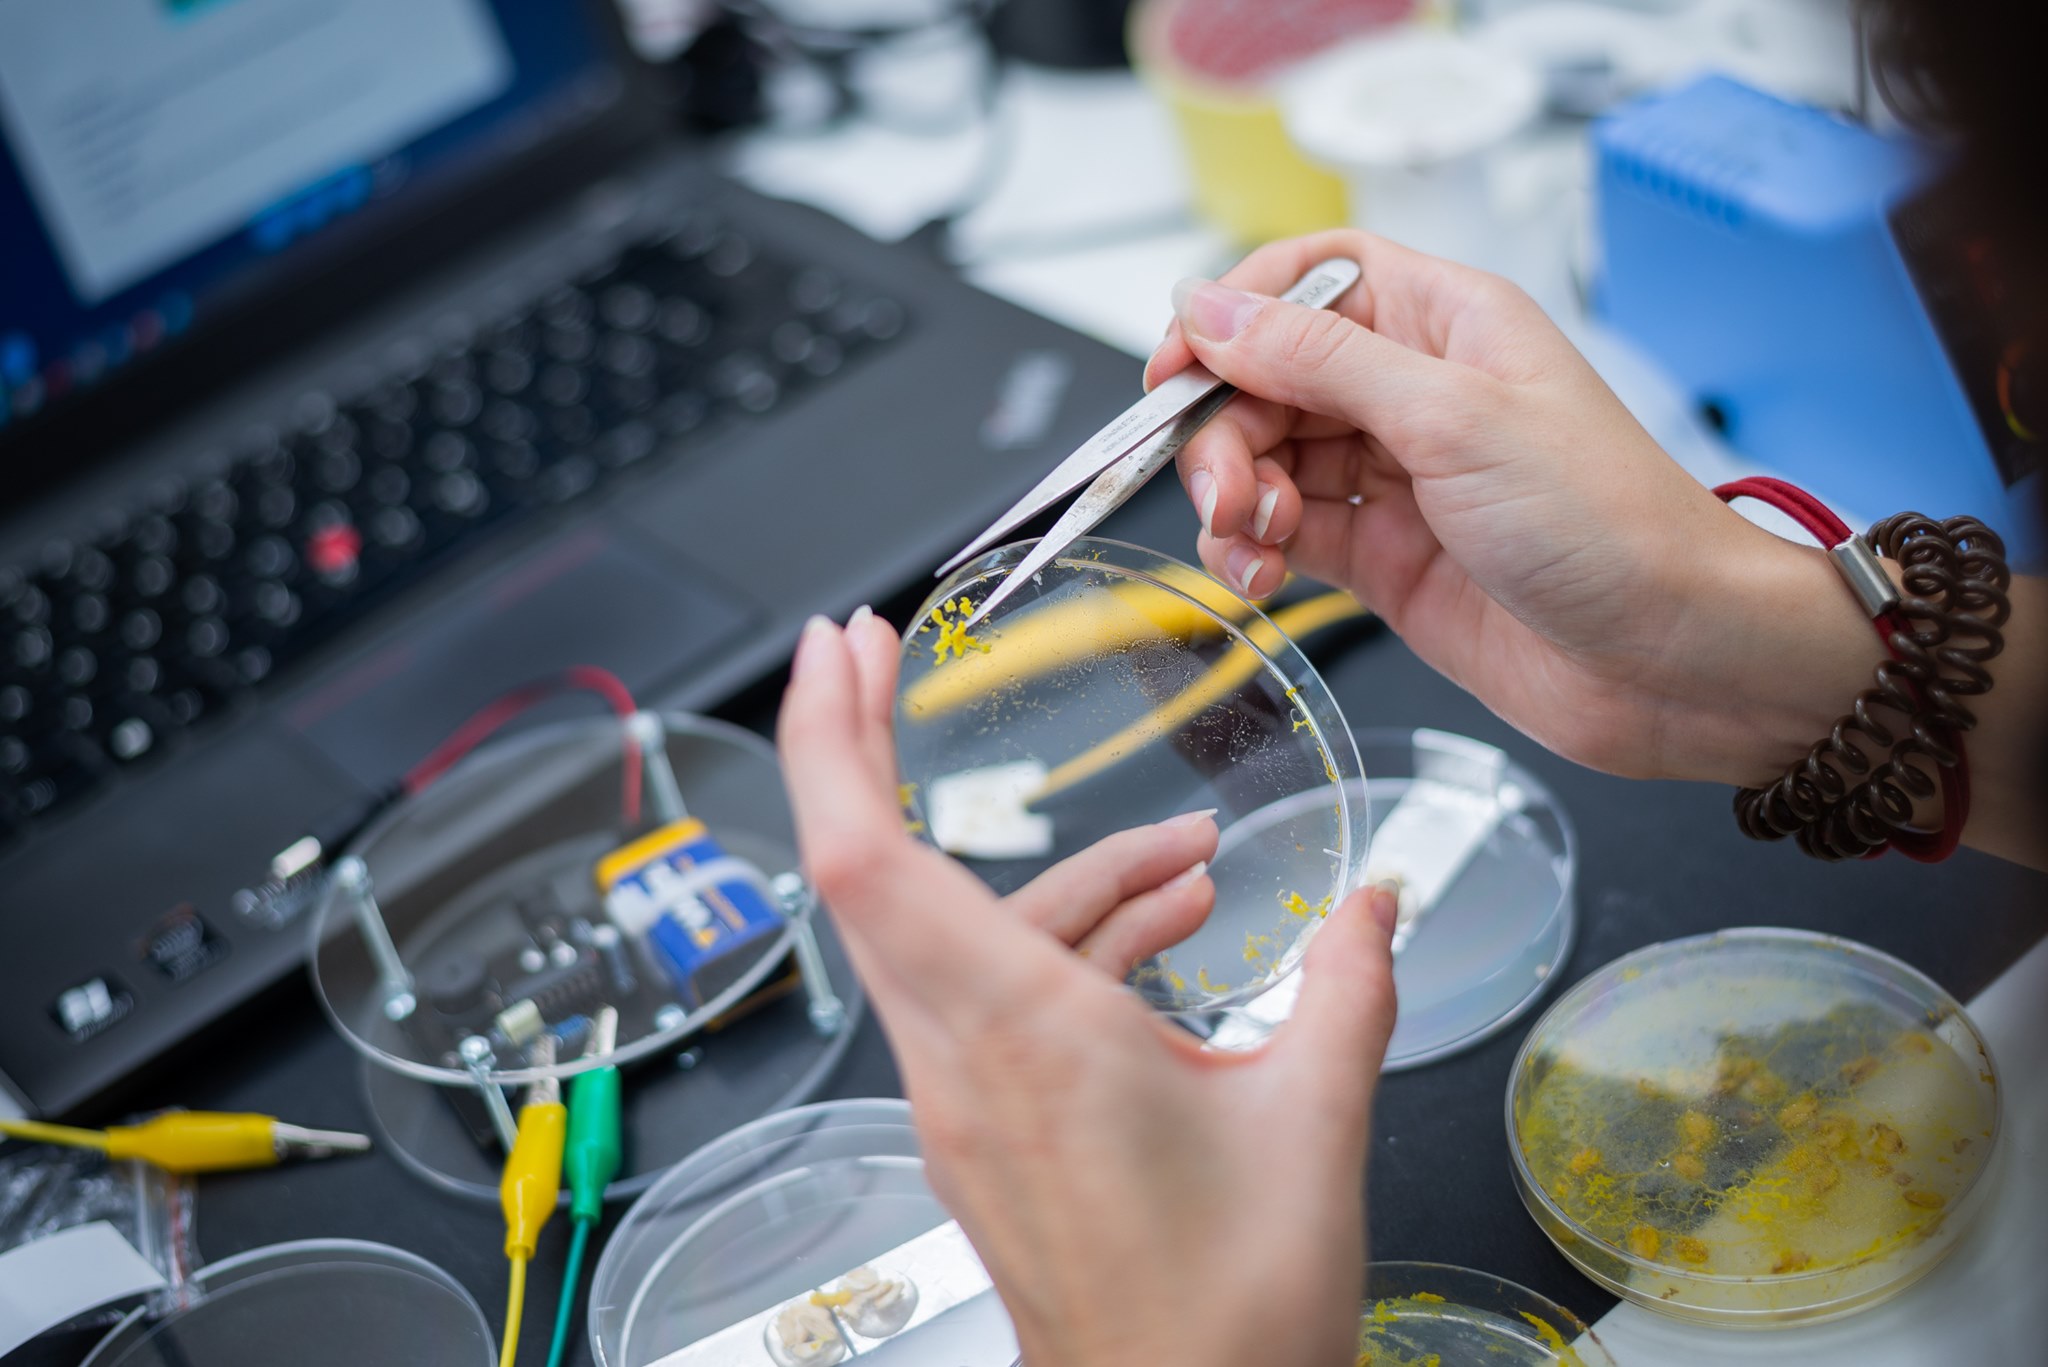

Delavnica Kons: SluZvok
16.05. in 18.05. 2022 od 17:00 do 19.00
Starost: 9-14
Delavnica SluZvok na zabaven in ustvarjalen način povezuje elektroniko, biologijo in umetno inteligenco.
Skupaj bomo podrobneje bodo spoznali sluzavke in zakaj so zanimive za raziskovanje tako za umetnike kot za znanstvenike. Udeleženci in udeleženke delavnice bodo ustvarili/e zvočilo, ki vključuje izdelavo oscilatorja in izdelavo tako imenovanih sluzotrod (elektrode, ki jih povezujejo sluzavke) preko katerih steče električni tok. Ker je ena od lastnosti sluzavk spreminjanje prevodnosti, jih bomo povezali z oscilatorjem, tako da bodo sluzavke ustvarjale zvok.
Na delavnici bodo udeleženci in udeleženke izvedeli/e vse o lastnostih sluzavk, ki kažejo na drugačno obliko inteligence, kako jih lahko sami gojijo ter na kakšne načine jih lahko vključujemo v elektronska vezja.
Delavnico sta razvila Eva Pondrk in Gregor Krpič, navdih pa sta črpala iz umetniškega dela ‘C T R L’ avtorja Michaela Sedbona.
Prijave še niso odprte.
Število mest je omejeno.
Delavnica
Datum in ura
16. maj
17:00


